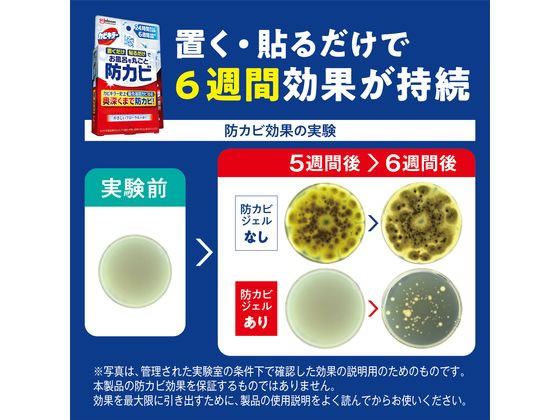
ジョンソン カビキラー置くだけ防カビジェル フローラル 付替え 2個 1個(ご注文単位1個)【直送品】

会員様限定 5,400円(税込)以上お買い上げで送料無料!
カテゴリから探す
- 紙袋(3,820)
- 箱(ギフトボックス)(5,956)
- ラッピング用品(34,398)
- ポリ袋(20,098)
- OPP袋(透明袋)(2,452)
- 食品容器・食品包装資材(55,418)
- キッチン用品・厨房用品(244,097)
- 衛生用品・清掃用品(66,834)
- 業務用食品・ギフト(17,868)
- 店舗用品(121,337)
- 文房具・事務用品(168,150)
- パソコン・OA用品(35,236)
- イベント用品(4,066)
- 手芸用品(23,298)
- フラワーアレンジメント資材・フラワーベース(17,718)
- 農業資材・園芸用品(9,714)
- 梱包資材(16,341)
- 物流資材・工場資材(574,802)
- 作業服・ワークウェア・安全靴(156,607)
- 医療・介護用品(56,769)
- 家電・店舗設備(17,552)
- 生活用品・日用雑貨(31,298)
- 研究開発用品・クリーンルーム用品(33,062)
- シモラボ〈特注品〉(2,908)
- シモラボ オフィス(1,884)
ジョンソン カビキラー置くだけ防カビジェル フローラル 付替え 2個 1個(ご注文単位1個)【直送品】
価格:¥1,336(税込)
価格(個単価): ¥1,336(税込)
- 商品コード:
- 2501601080418
次回の入荷は未定です
商品詳細
-
- 商品説明
- 浴室に置くだけで24時間防カビ&抗菌!6週間効果が持続!●浴室内に置くだけ、貼るだけ、吊るすだけの簡単操作。防カビ成分が常に空気中に放出され、狭い隙間やタイル目地の細孔の奥深くまで到達するため6週間しっかり効果が持続。食品香料にも使用される天然成分を使用しているため安心してお使いいただけます。●仕様:付け替え●内容量:2個●成分:香料、エッセンシャルオイル、色素●消防法:第4類、第三石油類、非水溶性、危険等級III、製品当たりの含有量16.0ml
※メーカーの都合により、パッケージ・仕様等は予告なく変更になる場合がございます。
-
- 小箱
- 1個(1個)
発送元
文具・事務用品関連02

- 本州
- ¥3,980以上で送料無料
¥3,980未満の場合¥880 - 北海道
- ¥3,980以上で送料無料
¥3,980未満の場合¥1,100

沖縄・離島配送不可

返品不可・日曜祝日指定不可
カビ取り剤の人気商品との比較
商品名
価格(税込)
サイズ
発送元
レビュー

ジョンソン カビキラー置くだけ防カビジェル フローラル 付替え 2個 1個(ご注文単位1個)【直送品】
¥1,336
【直送品】文具・事務用品関連02

※ご注文後、在庫がない場合キャンセル等のご連絡をさせていただきます。